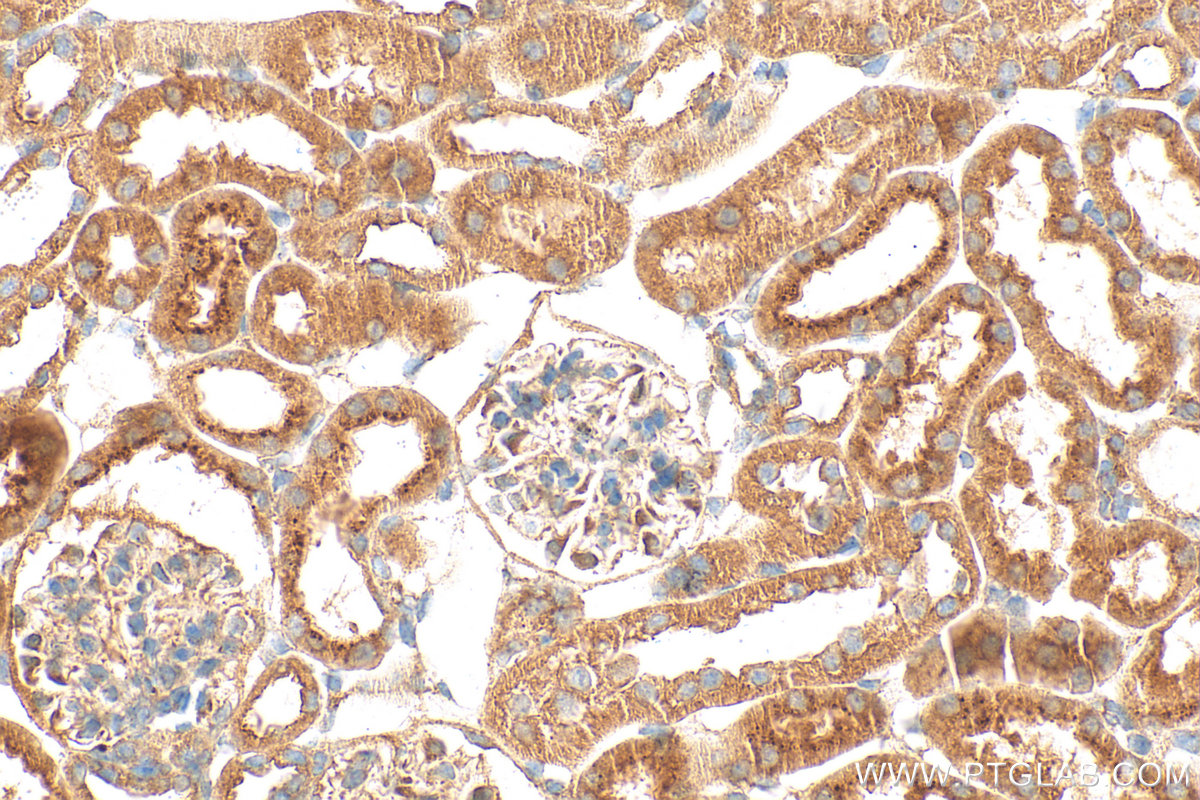
Immunohistochemistry (IHC) staining of mouse kidney tissue using Matrilin 2 Polyclonal antibody (24064-1-AP)

Tested Applications
| Positive WB detected in | NIH/3T3 cells, HEK-293 cells, mouse liver tissue |
| Positive IHC detected in | mouse kidney tissue Note: suggested antigen retrieval with TE buffer pH 9.0; (*) Alternatively, antigen retrieval may be performed with citrate buffer pH 6.0 |
Recommended dilution
| Application | Dilution |
|---|---|
| Western Blot (WB) | WB : 1:500-1:1000 |
| Immunohistochemistry (IHC) | IHC : 1:200-1:800 |
| It is recommended that this reagent should be titrated in each testing system to obtain optimal results. | |
| Sample-dependent, Check data in validation data gallery. | |
Published Applications
| KD/KO | See 1 publications below |
| WB | See 5 publications below |
| IF | See 1 publications below |
| CoIP | See 1 publications below |
Product Information
24064-1-AP targets Matrilin 2 in WB, IHC, IF, CoIP, ELISA applications and shows reactivity with human, mouse samples.
| Tested Reactivity | human, mouse |
| Cited Reactivity | human, mouse, zebrafish |
| Host / Isotype | Rabbit / IgG |
| Class | Polyclonal |
| Type | Antibody |
| Immunogen |
CatNo: Ag21113 Product name: Recombinant human MATN2 protein Source: e coli.-derived, PET30a Tag: 6*His Domain: 26-351 aa of BC010444 Sequence: RSRGRSISRGRHARTHPQTALLESSCENKRADLVFIIDSSRSVNTHDYAKVKEFIVDILQFLDIGPDVTRVGLLQYGSTVKNEFSLKTFKRKSEVERAVKRMRHLSTGTMTGLAIQYALNIAFSEAEGARPLRENVPRVIMIVTDGRPQDSVAEVAAKARDTGILIFAIGVGQVDFNTLKSIGSEPHEDHVFLVANFSQIETLTSVFQKKLCTAHMCSTLEHNCAHFCINIPGSYVCRCKQGYILNSDQTTCRIQDLCAMEDHNCEQLCVNVPGSFVCQCYSGYALAEDGKRCVAVDYCASENHGCEHECVNADGSYLCQCHEGFA Predict reactive species |
| Full Name | matrilin 2 |
| Calculated Molecular Weight | 107 kDa |
| Observed Molecular Weight | 120-150 kDa |
| GenBank Accession Number | BC010444 |
| Gene Symbol | Matrilin 2 |
| Gene ID (NCBI) | 4147 |
| RRID | AB_2879422 |
| Conjugate | Unconjugated |
| Form | Liquid |
| Purification Method | Antigen Affinity purified |
| UNIPROT ID | O00339 |
| Storage Buffer | PBS with 0.02% sodium azide and 50% glycerol, pH 7.3. |
| Storage Conditions | Store at -20°C. Stable for one year after shipment. Aliquoting is unnecessary for -20oC storage. 20ul sizes contain 0.1% BSA. |
Background Information
The matrilins represent a new family of oligomeric non-collagenous extracellular matrix proteins that are assumed to act as adapter molecules connecting other proteins and proteoglycans in the extracellular matrix (PMID: 17513098). Four matrilins (matrilin-1, -2, -3, and -4) have been identified. They all share a structure made up of von Willebrand factor A domains, EGF-like domains and a coiled-coil alpha-helical module (PMID: 18386166). Matrilin-1 and matrilin-3 are expressed mainly in cartilage, while matrilin-2 and matrilin-4 show broader tissue distribution. Matrilin-2 is the largest member of the family. It incorporates into loose and dense connective tissue and becomes associated with some basement membranes (PMID: 17513098).
Protocols
| Product Specific Protocols | |
|---|---|
| IHC protocol for Matrilin 2 antibody 24064-1-AP | Download protocol |
| WB protocol for Matrilin 2 antibody 24064-1-AP | Download protocol |
| Standard Protocols | |
|---|---|
| Click here to view our Standard Protocols |
Publications
| Species | Application | Title |
|---|---|---|
Sci Adv A basement membrane discovery pipeline uncovers network complexity, regulators, and human disease associations.
| ||
J Mol Med (Berl) Valproic acid modulates collagen architecture in the postoperative conjunctival scar. | ||
Funct Integr Genomics MATN2 overexpression suppresses tumor growth in ovarian cancer via PTEN/PI3K/AKT pathway | ||
Ann Vasc Surg The Mechanism of Matrilin-2 Inhibiting the Progression of In-Stent Restenosis for Lower Extremity Arteriosclerosis Obliterans via TGF-β/Smad Signaling Pathway | ||
Int J Mol Sci A Regulator Role for the ATP-Binding Cassette Subfamily C Member 6 Transporter in HepG2 Cells: Effect on the Dynamics of Cell-Cell and Cell-Matrix Interactions | ||
Biomedicines Therapeutic Target Discovery for Multiple Myeloma: Identifying Druggable Genes via Mendelian Randomization |